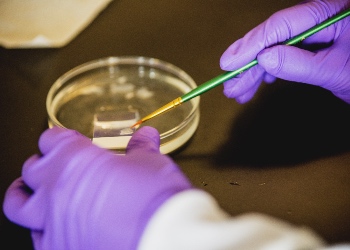

The CMRC is a shared facility that is available to investigators within the Department of Biomedical Sciences to conduct cellular (in vitro) and molecular experiments. All operators that use the core must go through an orientation before their first day in the facility and must comply with the core rules at all times.
A respectful and cooperative environment is the best formula for productive and successful research.
Facility general rules
- NEW Core operators, students and lab technicians, must be certified by Dr. Makky before they start working in the core to receive specific instructions about the facility.
- Each user must sign in daily before using the core. Signing sheet is located behind the core main door.
- This is a molecular research facility. Therefore, NO animals are permitted in the facility. NO ITEMS which have been in contact with animals or animal waste are permitted in the facility
- Radiation work is not allowed in the facility.
- Food or drinks are NOT PERMITTED in the facility at ANY TIME. This includes water bottles and snack bags.
Cell culture rules
- Users must notify Dr. Makky that they intend to use the culture room. Users must receive specific instructions and assigned space in the incubator prior to using the facility.
- Users must sign up on the sign-in sheet. When you sign up for the hood write your name, date and time, PI name, your phone number, and the duration of time you need the hood. Please respect the fact that it is a shared space and do not sign up for more time than you need.